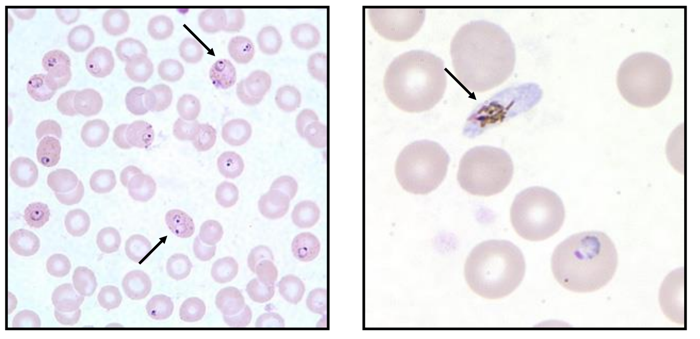
Enunciado 3536776-1

Foram encontradas 30 questões.
A Assistência Farmacêutica (AF) reúne um conjunto de ações voltadas à promoção, proteção e
recuperação da saúde, por meio da promoção do acesso aos medicamentos e uso racional. No Ministério
da Saúde, tais ações consistem em promover a pesquisa, o desenvolvimento e a produção de
medicamentos e insumos, bem como sua seleção, programação, aquisição, distribuição e avaliação de
sua utilização, na perspectiva da obtenção de resultados concretos e da melhoria da qualidade de vida
da população. Sendo assim, é correto afirmar que
Provas
Questão presente nas seguintes provas
A RDC 302 (2005) dispõe sobre Regulamento Técnico para funcionamento de Laboratórios Clínicos. Essa
norma define, em seus artigos 4º e 6º,
"4.11 Controle da qualidade: Técnicas e atividades operacionais utilizadas para monitorar ocumprimento dos requisitos da qualidade especificados.
4.12 Controle externo da qualidade - CEQ: Atividade de avaliação do desempenho de sistemas analíticos através de ensaios de proficiência, análise de padrões certificados e comparações interlaboratoriais.Também chamada Avaliação Externa da Qualidade.
4.13 Controle interno da qualidade - CIQ: Procedimentos conduzidos em associação com o exame de amostras de pacientes para avaliar se o sistema analítico está operando dentro dos limites de tolerância pré-definidos. (…)
6.2.6 O laboratório clínico deve monitorar a fase analítica por meio de controle interno e externo da qualidade.”
Considere o Gráfico de Levey-Jennings que revela os resultados de uma corrida analítica em função do tempo ou do número de corridas.
Adaptado de: http://www.pncq.org.br/uploads/2015/workshops_aulas/Controle
A observação do gráfico permite inferir que o analito
"4.11 Controle da qualidade: Técnicas e atividades operacionais utilizadas para monitorar ocumprimento dos requisitos da qualidade especificados.
4.12 Controle externo da qualidade - CEQ: Atividade de avaliação do desempenho de sistemas analíticos através de ensaios de proficiência, análise de padrões certificados e comparações interlaboratoriais.Também chamada Avaliação Externa da Qualidade.
4.13 Controle interno da qualidade - CIQ: Procedimentos conduzidos em associação com o exame de amostras de pacientes para avaliar se o sistema analítico está operando dentro dos limites de tolerância pré-definidos. (…)
6.2.6 O laboratório clínico deve monitorar a fase analítica por meio de controle interno e externo da qualidade.”
Considere o Gráfico de Levey-Jennings que revela os resultados de uma corrida analítica em função do tempo ou do número de corridas.

Adaptado de: http://www.pncq.org.br/uploads/2015/workshops_aulas/Controle
A observação do gráfico permite inferir que o analito
Provas
Questão presente nas seguintes provas
A Resolução da Diretoria Colegiada 166 (RDC 166) de 2017 dispõe sobre a validação de métodos
analíticos e dá outras providências. No anexo I, encontram-se os parâmetros a serem considerados na
validação analítica. Entre eles, estão
Provas
Questão presente nas seguintes provas
Em um dia de rotina na bancada de urinálise, o estagiário que acompanha o serviço observou na
microscópia, durante o exame de sedimento, muitas bactérias e interrogou o analista como era possível,
pois a avaliação de nitrito da tira reativa estava negativa. O analista solicitou ao seu pupilo a execução de
uma coloração de Gram da urina analisada a fim de explicá-lo o porquê. Prontamente, o estagiário
preparou a lâmina e a avaliou ao microscópio observando,
Provas
Questão presente nas seguintes provas
O nascimento da Imunologia como ciência coincide com a vacinação bem-sucedida contra a varíola,
realizada em 1796 por Edward Jenner. A importância da imunização profilática contra doenças infecciosas
é bem ilustrada por programas internacionais de vacinação que levaram à completa ou quase completa
erradicação de muitas dessas doenças em países desenvolvidos como também no controle da pandemia
recente por SARS-COV-2, por exemplo. O sucesso da vacinação na erradicação de doenças infecciosas
depende de várias propriedades dos microrganismos. Há vários tipos de vacinas que atuam induzindo
produção de anticorpos. Quanto às distintas metodologias vacinais, é correto afirmar que
Provas
Questão presente nas seguintes provas
O diagnóstico e o monitoramento do diabetes continuam centrados em torno da concentração da glicose
sanguínea. Duas medidas são amplamente utilizadas para tais finalidades: a medida direta da glicose e
a de hemoglobina glicada. Quando o diagnóstico do diabetes não está claro, o médico solicita exames
complementares. A imagem abaixo é ilustrativa de um exame complementar. 
Tempo em horas após ingestão de 75g de glicose Fonte: Elaborador
Esse exame corresponde

Tempo em horas após ingestão de 75g de glicose Fonte: Elaborador
Esse exame corresponde
Provas
Questão presente nas seguintes provas
Um paciente chegou ao laboratório com requisição para diversos exames de sangue. O técnico de
laboratório foi consultar o analista clínico para lhe recordar quais tubos precisavam ser utilizados. O
analista leu a requisição e verificou que os exames solicitados eram glicemia de jejum, hemograma
completo, colesterol total e frações, aspartato aminotransferase, alanina aminotransferase, hemoglobina
glicada, ureia, creatinina, tempo de atividade da protrombina, tempo de tromboplastina parcial ativada e
fibrinogênio. Considerando esses exames e a sequência correta de coleta, o analista deve instruir o
técnico a iniciar coletando no tubo
Provas
Questão presente nas seguintes provas
As imagens abaixo representam dois campos observados pelo analista clínico durante seu dia a dia, na
bancada de hematologia. 
Figura 1 e 2. Fonte: https://www.cdc.gov/dpdx/malaria/index.html
As setas apontam para estruturas morfológicas características (trofozoítos em forma de anel e gametócito) do parasita
Figura 1 e 2. Fonte: https://www.cdc.gov/dpdx/malaria/index.html
As setas apontam para estruturas morfológicas características (trofozoítos em forma de anel e gametócito) do parasita
Provas
Questão presente nas seguintes provas
O analista clínico da unidade de saúde foi convidado a inspecionar o armazém onde estavam guardados
alimentos para a realização de um evento durante a semana de conscientização do diabetes. No local,
ele observou a presença de muitos bolores nas paredes e próximo aos alimentos. Em conversa com a
equipe multidisciplinar da unidade, alertou sobre a possível presença de micotoxinas nos alimentos mal
acondicionados. Convidado a explicar como se faz para avaliar a presença de toxinas nos alimentos, ele
sugeriu a utilização de um método de análise que utiliza cromatografia para determinar a presença do
agente tóxico. Por fim, ele esclareceu que a cromatografia é um método
Provas
Questão presente nas seguintes provas
A figura abaixo ilustra o teste de B-HCG de quatro pacientes: Ana, Bete, Cida e Diva.

Adaptado de: http://ebram.com/assets/606.intuse.pdf
Com base na interpretação dos testes, deve-se concluir que
Provas
Questão presente nas seguintes provas
Cadernos
Caderno Container